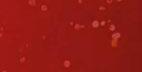

![]()













































































































































































































































































































• 2 lbs. lamb or beef
• 6 cups broth





• 1 tbsp. olive oil divided
• 1 lg. onion diced
• 3 celery stalks diced
• 10 oz. mushrooms sliced
• 6 sm. potatoes peeled/ cubed
• 3 sm. turnips peeled/ cubed
• 3 med. carrots sliced
• 1 1/4 c. lentils rinsed
• 3 tbsp. tomato paste
• 2 tsp. Dijon mustard
• 2 tsp. paprika
• 1 tbsp. sugar
• 1 tsp. salt & pepper

Soda Bread Ingredients:

• 4 cups all-purpose our
• 1/2 cup margarine, softened
• 4 tablespoons white sugar
• 1 teaspoon baking soda
• 1 tablespoon baking powder
• 1/2 teaspoon salt
• 1 cup buttermilk
• 1 egg
• 1/4 cup butter, melted
• 1/4 cup buttermilk




















Prepare ingredients. Trim excess fat from the lamb or beef and cut it into bite-sized pieces. Sear the Meat. Add a small amount of oil and brown the meat in batches, ensuring a golden crust. Heat half tablespoon olive oil in a large pot over medium heat. Add onion and celery and cook 5 to 7 minutes until softened. Add mushrooms and cook 5 minutes until lightly browned. Add meat, potatoes, turnips, carrots, and lentils. Stir in tomato paste, Dijon mustard, paprika, sugar, salt, and black pepper. Slowly pour in broth while stirring. Bring to a boil then reduce heat to low and cover. Simmer 1.5-2 hours, stirring occasionally. The stew is ready when the meat is tender & potatoes have thickened the broth.













Preheat the oven to 375o. Lightly grease a large baking sheet.

Mix our, softened margarine, sugar, baking soda, baking powder, and salt together in a large bowl. Stir in 1 cup of buttermilk and egg. Turn dough out onto a lightly oured surface and knead slightly. Form dough into a round and place on the prepared baking sheet.

Combine melted butter with 1/4 cup buttermilk in a small bowl; brush loaf with this mixture. Use a sharp knife to cut an “X” into the top of the loaf.
Bake in preheated oven until a toothpick inserted into the center of the loaf comes out clean, 45-50 min. Check for doneness after 30 min. You may continue to brush the loaf with the butter mixture while it bakes.








No-bake Grasshopper Pie



• 25 chocolate sandwich cookies

• ½ cup butter, melted

• 2 cups marshmallow u
• ¼ cup crème de menthe liqueur
• 2 cups whipping cream








Crush cookies. Set aside 1/4 cup of crumbs. Place remaining crumbs in a medium bowl and mix in melted butter; press mixture rmly into the bottom and sides of a 9” pie pan. Mix marshmallow u and crème de menthe together in a large mixing bowl until smooth. Beat cream in a chilled glass or metal bowl with an electric mixer until soft peaks form; fold into marshmallow mixture. Pour mixture into prepared crust and sprinkle reserved cookie crumbs on top. Freeze until rm, at least 2 hours. Remove from freezer 20 minutes before serving to soften slightly.

Brought to you by:



















For advertising information, call Bill 419-346-6177 NEXT ISSUE IN HOMES: April 3, 2026
ADVERTISING DEADLINE: March 18, 2026











































































































